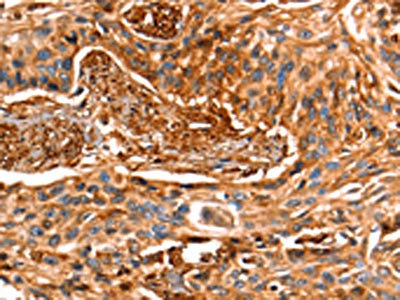

LGALS1 Antibody
-
中文名稱:LGALS1兔多克隆抗體
-
貨號:CSB-PA794383
-
規格:¥1100
-
圖片:
-
The image on the left is immunohistochemistry of paraffin-embedded Human cervical cancer tissue using CSB-PA794383(LGALS1 Antibody) at dilution 1/25, on the right is treated with fusion protein. (Original magnification: ×200)
-
The image on the left is immunohistochemistry of paraffin-embedded Human esophagus cancer tissue using CSB-PA794383(LGALS1 Antibody) at dilution 1/25, on the right is treated with fusion protein. (Original magnification: ×200)
-
Gel: 12+15%SDS-PAGE, Lysate: 40 μg, Lane: Human fetal muscle tissue, Primary antibody: CSB-PA794383(LGALS1 Antibody) at dilution 1/500, Secondary antibody: Goat anti rabbit IgG at 1/8000 dilution, Exposure time: 10 seconds
-
-
其他:
產品詳情
-
Uniprot No.:
-
基因名:
-
別名:14 kDa laminin-binding protein antibody; 14 kDa lectin antibody; Beta galactoside binding lectin antibody; Beta galactoside binding lectin L 14 I antibody; beta galactoside binding protein antibody; Beta-galactoside-binding lectin L-14-I antibody; DKFZp686E23103 antibody; Gal 1 antibody; Gal-1 antibody; GAL1 antibody; Galaptin antibody; Galbp antibody; Galectin antibody; Galectin-1 antibody; Galectin1 antibody; GBP antibody; HBL antibody; HLBP14 antibody; HPL antibody; L 14.5 antibody; L-14.5 antibody; L14 antibody; Lactose binding lectin 1 antibody; Lactose-binding lectin 1 antibody; Lect14 antibody; Lectin galactoside binding soluble 1 antibody; Lectin galactoside-binding soluble 1 antibody; LEG1_HUMAN antibody; LGALS 1 antibody; LGALS1 antibody; Lgals1 lectin galactose binding soluble 1 antibody; MAPK activating protein MP12 antibody; Putative MAPK activating protein MP12 antibody; Putative MAPK-activating protein PM12 antibody; S Lac lectin 1 antibody; S-Lac lectin 1 antibody
-
宿主:Rabbit
-
反應種屬:Human,Mouse,Rat
-
免疫原:Fusion protein of Human LGALS1
-
免疫原種屬:Homo sapiens (Human)
-
標記方式:Non-conjugated
-
抗體亞型:IgG
-
純化方式:Antigen affinity purification
-
濃度:It differs from different batches. Please contact us to confirm it.
-
保存緩沖液:-20°C, pH7.4 PBS, 0.05% NaN3, 40% Glycerol
-
產品提供形式:Liquid
-
應用范圍:ELISA,WB,IHC
-
推薦稀釋比:
Application Recommended Dilution ELISA 1:1000-1:5000 WB 1:500-1:2000 IHC 1:25-1:100 -
Protocols:
-
儲存條件:Upon receipt, store at -20°C or -80°C. Avoid repeated freeze.
-
貨期:Basically, we can dispatch the products out in 1-3 working days after receiving your orders. Delivery time maybe differs from different purchasing way or location, please kindly consult your local distributors for specific delivery time.
-
用途:For Research Use Only. Not for use in diagnostic or therapeutic procedures.
相關產品
靶點詳情
-
功能:Lectin that binds beta-galactoside and a wide array of complex carbohydrates. Plays a role in regulating apoptosis, cell proliferation and cell differentiation. Inhibits CD45 protein phosphatase activity and therefore the dephosphorylation of Lyn kinase. Strong inducer of T-cell apoptosis.
-
基因功能參考文獻:
- Silencing Gal-1 impaired invasiveness, and decreased S1PR1 expression and overexpression in gastric cancer can promote the expression of S1PR1and invasion of gastric cancer cells. PMID: 30453284
- Association of galectin-1 expression with eosinophilic infiltration of the tumor tissue in stomach and colorectal cancer was detected. PMID: 29926280
- Study shows that recombinant Galectin-1 (Gal-1) could promote the differentiation and invasion of Trophoblast stem cells (TSCs), suggesting that some of Ishikawa cells secretion increase the expression of Gal-1 in TSCs during implantation, which then induced trophoblast differentiation and invasion in vitro. PMID: 28826368
- In conclusion, these findings suggest that the serum levels of Gal-1, Gal-3, and Gal-9 may be associated with large artery atherosclerotic stroke. PMID: 28112232
- High LGALS1 expression is associated with fibrosis in chronic pancreatitis and pancreatic cancer. PMID: 29328490
- Pancreatic stellate cells promote cancer proliferation, migration, and invasion via Gal1-driven pathways. Gene-expression analyses of pancreatic tumor cells exposed to Gal1 reveal modulation of multiple regulatory pathways involved in tumor progression. PMID: 29615514
- Studies indicate tumor-derived galectin-1, galectin-3 and galectin-9 in various cancers and anticancer therapies that target these molecules [Review]. PMID: 29389859
- The expression level of galectin-1 affects survival in patients with glioblastoma multiforme treated with adjuvant radiotherapy PMID: 29378529
- Results show that Galectin-1 teams up with Galectin-3 to induce inflammatory/pro-degradative gene signature in human chondrocytes affecting the progression of osteoarthritis. Also, Galectin-3 was found to induce a pro-degradative-inflammatory gene signature in human chondrocytes, teaming up with Galectin-1 in the pathogenesis of osteoarthritis. PMID: 27982117
- We also found a subset of prostate cancer patient-derived xenografts and prostate cancer patient samples with mild HO-1 and low Gal-1 expression levels. These results highlight a novel function of a human-used drug as a means of boosting the antitumor response PMID: 28512172
- Gal-1, Gal-3 and Gal-9 galectin expression was higher in the myenteric plexus ganglia of chagasic patients PMID: 28554765
- Results have shown that Gal-1 in the farnesyl-bound form acquires the ability to form self-clusters, and the galactoside-binding pocket of Gal-1 in the FTS-bound form plays an important role in self-cluster formation. PMID: 27624845
- Our findings support the introduction of galectin-1 as a reliable diagnostic marker for thyroid carcinomas. Its involvement in cell proliferation, migration, invasion and tumor growth also intimate functional involvement of galectin-1 in the progression of thyroid carcinoma, suggesting its potential as a therapeutic target PMID: 28677745
- This study showed that obese children had significantly higher galectin-1 levels in proportion to fat mass in obese cases than those in healthy children, which may be interpreted as a compensatory increase in an attempt to improve glucose metabolism. PMID: 28728946
- We further demonstrated using the NMR-based hydrogen-deuterium exchange (HDX) that lactose binding increases the exchange rates of residues located on the opposite side of the ligand-binding pocket for hGal1 and hGal8(NTD), indicative of allostery. Additionally, lactose binding induces significant stabilisation of hGal8(CTD) across the entire domain PMID: 28813004
- our findings indicate that galectin-1 plays a pivotal role in the regulation of key processes in cancer cells, such as migration, invasion, and chemoresistance, by modulating FAK and ERK signaling and survivin level. PMID: 28415760
- Gal-3 staining in the nucleus could be a new positive prognosticator for ovarian cancer. PMID: 28594391
- Gal-1 may offer an additional therapeutic target linking anti-angiogenesis and immune checkpoint blockade. PMID: 28473314
- markedly increased brain Gal-1 and S-nitrosylated Gal-1 both in scrapie-infected rodents and human prion diseases. PMID: 27211330
- Gal-1 knockdown dramatically improved drug sensitivity of breast cancer by reducing P-glycoprotein (P-gp) expression via inhibiting the Raf-1/AP-1 pathway, providing a novel therapeutic target to overcome MDR in breast cancer. PMID: 28212576
- the immunosuppressive microenvironment promoted by hepatic stellate cell-derived galectin-1 in hepatocellular carcinoma can be inhibited by miR-22 PMID: 27494859
- Galectin-1 promotes invasion and epithelial mesenchymal transformation in gastric cancer cells via activation of the non-canonical Hh pathway in Gli-1 dependent manner. PMID: 27835885
- Gal-1 level retained independent predictive influence on the risk of developing cGvHD PMID: 27214079
- this study identified 131 Gal-3 and 15 Gal-1 interactors by galectin pulldown experiments combined with quantitative proteomics. PMID: 28576849
- we found that galectin-1 was a novel modulator of MDR1 by proteomic analysis of a model system of leukemia cell lines PMID: 27050374
- Data found Gal-1 to induce EMT and gastric cancer (GC) cell migration and invasion. Also, Gal-1 up-regulated Gli1 expression and beta1 integrin was responsible for Gal-1-induced Gli1 expression and EMT. PMID: 27836001
- Galectin-1-driven production of SDF-1 in pancreatic stellate cells through activation of NF-kappaB promotes metastasis in pancreatic ductal adenocarcinoma. PMID: 28336327
- Gal-1 expression by MM cells was upregulated in hypoxic conditions and stable knockdown of hypoxia inducible factor-1alpha significantly downregulated its expression PMID: 27311934
- Gal1 may be a useful marker for determining whether morphologic changes in oral cells are reactive or neoplastic PMID: 26980012
- The aim of this study was to analyze the syncytium formation abilities of BeWo cells that were gal-1 silenced. PMID: 26418280
- Studies provide evidence that galectin-1 belongs to the group of potential pathogenic molecules in systemic lupus erythematosus. [review] PMID: 28100106
- an intact dimer interface of Gal-1 is required for it to positively regulate H-rasG12V nanoclustering, but negatively K-rasG12V nanoclustering. PMID: 27087647
- Our results suggest that Gal-1 and ASPP2 functionally compete in nanocluster for active Ras on the plasma membrane. ASPP2 dominates the biological outcome, thus switching from a Gal-1 supported growth-promoting setting to a senescence inducing and stemness suppressive program in cancer cells. Our results support Ras nanocluster as major integrators of tumour fate decision events. PMID: 27437940
- Galectin-1 and Galectin-3 are novel-binding partners for human FVIII. Gal-1 binding can influence the procoagulant activity of FVIII. PMID: 27013611
- Proteomics of the interstitial fluid in subcutaneous adipose tissue in vivo identified a novel adipokine, galectin-1, with a potential role in the pathophysiology of type 2 diabetes. PMID: 27282870
- Suggest that galectin-1 is a protective factor against the development of digital vasculopathy in systemic sclerosis. PMID: 24517166
- This study demonstrated that TLR-mediated PI3K activation modulated the invasion and metastasis of ovarian cancer through the production of galectin-1. PMID: 28350104
- Gal-1-regulated carcinoma-associated fibroblast activation promotes breast cancer cell metastasis by upregulating MMP-9 expression. PMID: 27025601
- It is a beta-galactose-binding animal lectin and known to be distributed throughout the body. PMID: 27590897
- Our functional analyses of galectin-1 in urinary bladder urothelial carcinoma provided novel insights into the critical role of galectin-1 in tumor progression and invasion. These results revealed that silencing the galectin-1-mediated MAPK signaling pathway presented a novel strategy for bladder cancer therapy. PMID: 27440446
- the TLR4/Gal-1 signaling pathway regulates lactate-mediated EMT processes through the activation of ADAM10 and ADAM17 in colon cancer cells. PMID: 27837433
- These findings suggest that Gal-1 plays an important role in immune escape of gingival squamous cell carcinoma cells, and Gal-1 expression level may be a useful clinicopathological prognostic marker for this cancer. PMID: 28108653
- Galectin-1 gene silencing would improve the sensitivity of A549/DDP cells to cisplatin in vivo and in vitro. PMID: 27392028
- In this study, gal-1, -2, -3 and -13 were investigated systematically in the trophoblast and decidua compartment of intrauterine growth restriction (IUGR) placentas and normal third trimester control placentas and stratified by fetal gender and gestational age. Gal-1 Expression Shows No Significant Changes in IUGR Placentas in Villous Trophoblasts. PMID: 27070577
- Galectin-1 overexpression activates the FAK/PI3K/AKT pathway by upregulating expression of alphavbeta3 integrin, leading to enhanced hepatocellular carcinoma invasion via epithelial-mesenchymal transition and sorafenib resistance. PMID: 27100895
- results show that HELLP syndrome is associated with increased circulating levels of gal-1 PMID: 26956510
- The integrative analysis of galectins(Gal-1, -3, -4, -9) discriminated IBD from other intestinal inflammatory conditions and could be used as potential mucosal biomarker PMID: 26891020
- Galectin-1 was undetectable in normal and ulcerative colitis colonic epithelium, while galectin-2, galectin-3, and galectin-4 were strongly expressed. PMID: 26885508
- Tumor-driven, unremitting expression of Satb1 in activated Zbtb46+ inflammatory dendritic cells that infiltrate ovarian tumors results in an immunosuppressive phenotype characterized by increased secretion of tumor-promoting Galectin-1 and IL-6. PMID: 26876172
- Epithelial immunostaining for galectin-1 tended to be elevated in fallopian tubes from women with ectopic pregnancy. PMID: 26359845
顯示更多
收起更多
-
亞細胞定位:Secreted, extracellular space, extracellular matrix. Cytoplasm. Secreted.
-
組織特異性:Expressed in placenta, maternal decidua and fetal membranes. Within placenta, expressed in trophoblasts, stromal cells, villous endothelium, syncytiotrophoblast apical membrane and villous stroma. Within fetal membranes, expressed in amnion, chorioamnioti
-
數據庫鏈接:
Most popular with customers
-
-
YWHAB Recombinant Monoclonal Antibody
Applications: ELISA, WB, IHC, IF, FC
Species Reactivity: Human, Mouse, Rat
-
-
-
-
-
-